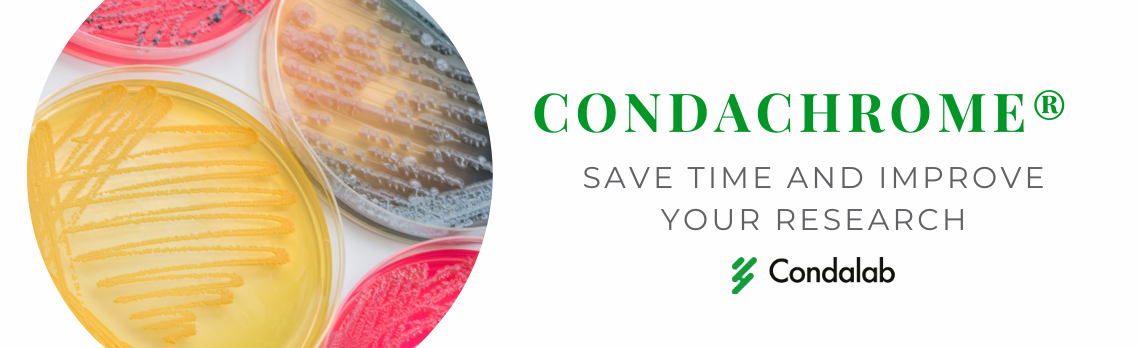

Culture Media - CondaChrome®
Culture Media - CondaChrome®
Discover CondaChrome®, a line of chromogenic media produced by Condalab that will improve the accuracy of results in your laboratory. The culture media products have a colourless chromogenic substrate in their composition from the specific enzymatic activity of each microorganism. A part called the chromophore is realised to give the colony an intense and specific colour that makes it possible to identify the bacteria instantly. This culture media offers a series of advantages to save time in identifying your crops.
The CondaChrome® line became known when Condalab, saw an opportunity in the cosmetics market due to the need for strict control over the microorganisms. This culture media facilitates the simultaneous detection of three of the four pathogens mentioned above. By using the chromogenic media, CondaChrome® PEC, quality control and sample analysis in the cosmetic industry are simplified and it reduces the time spent on processes and techniques that are originally used, from 5 to 8 days reduced to 3 to 5 days. It can also be applied to the water, food, and clinical industries.
What is the Basis of CondaChrome®’s technology?
-Culture media – the importance of the nutrients and selective components
-CondaChrome® chromogenic substrates – the colourless substrates that are degraded to give the intense and specific colour for identification
-Bacterial enzymes activity – Release of chromophores by specificity of enzymatic reactions
Advantages of CondaChrome® Culture Media:
Quick results
in 24 hours, you can collect the results in the culture medium
Easy identification
can be identified at a balance due to the bacteria grown in the culture media
Saving time
identifying different bacterial species is easy
Greater selectivity
More selective line of media than traditional culture media
High detection
capable of detecting bacteria even with low concentrations
Simple protocol
Inoculate it directly from the sample or enrichment broth
Wide product range
Wide range of products and specific culture media to comply with your microorganism sample
Want to know more about CondaChrome® Chromogenic Media?
Our experts in Life Science would be happy to answer all your questions about the CondaChrome® range and how it can improve your research and efficiency in the laboratory!
|
To Find Out More |
